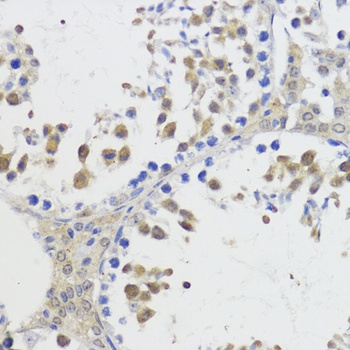
Akt2 Antibody

You have no items in your shopping cart.
Search results for: 'AKT2'
- AKT2 Rabbit Polyclonal Antibody [orb11297]Featured

IF, IHC-Fr, IHC-P, WB
Human, Mouse, Rat
Mouse, Rat
Rabbit
Polyclonal
Unconjugated
100 μl, 200 μl, 50 μl - Human Protein Kinase B Beta (PKBb) ELISA Kit [orb776025]Featured

Human
0.32-20 ng/mL
0.128 ng/mL
48 T, 96 T - Akt (phospho Thr308) rabbit pAb [orb764338]Featured

ELISA, IF, IHC-P, WB
Human, Mouse, Rat
Polyclonal
Unconjugated
100 μl, 50 μl - Akt2 rabbit pAb [orb764511]Featured

ELISA, IF, IHC-P, WB
Human, Mouse, Rat
Polyclonal
Unconjugated
50 μl, 100 μl - Rat Protein Kinase B Beta (PKBb) ELISA Kit [orb780564]Featured

Rat
0.32-20 ng/mL
0.113 ng/mL
48 T, 96 T - Featured

IF, IHC-Fr, IHC-P, WB
Human, Mouse, Rat
Human, Mouse, Rat
Rabbit
Recombinant
Unconjugated
25 μl, 50 μl, 100 μl - AKT2 Antibody (C-term) [orb1929631]
FC, IF, IHC-P, WB
Human
Mouse, Rat
Rabbit
Polyclonal
Unconjugated
400 μl